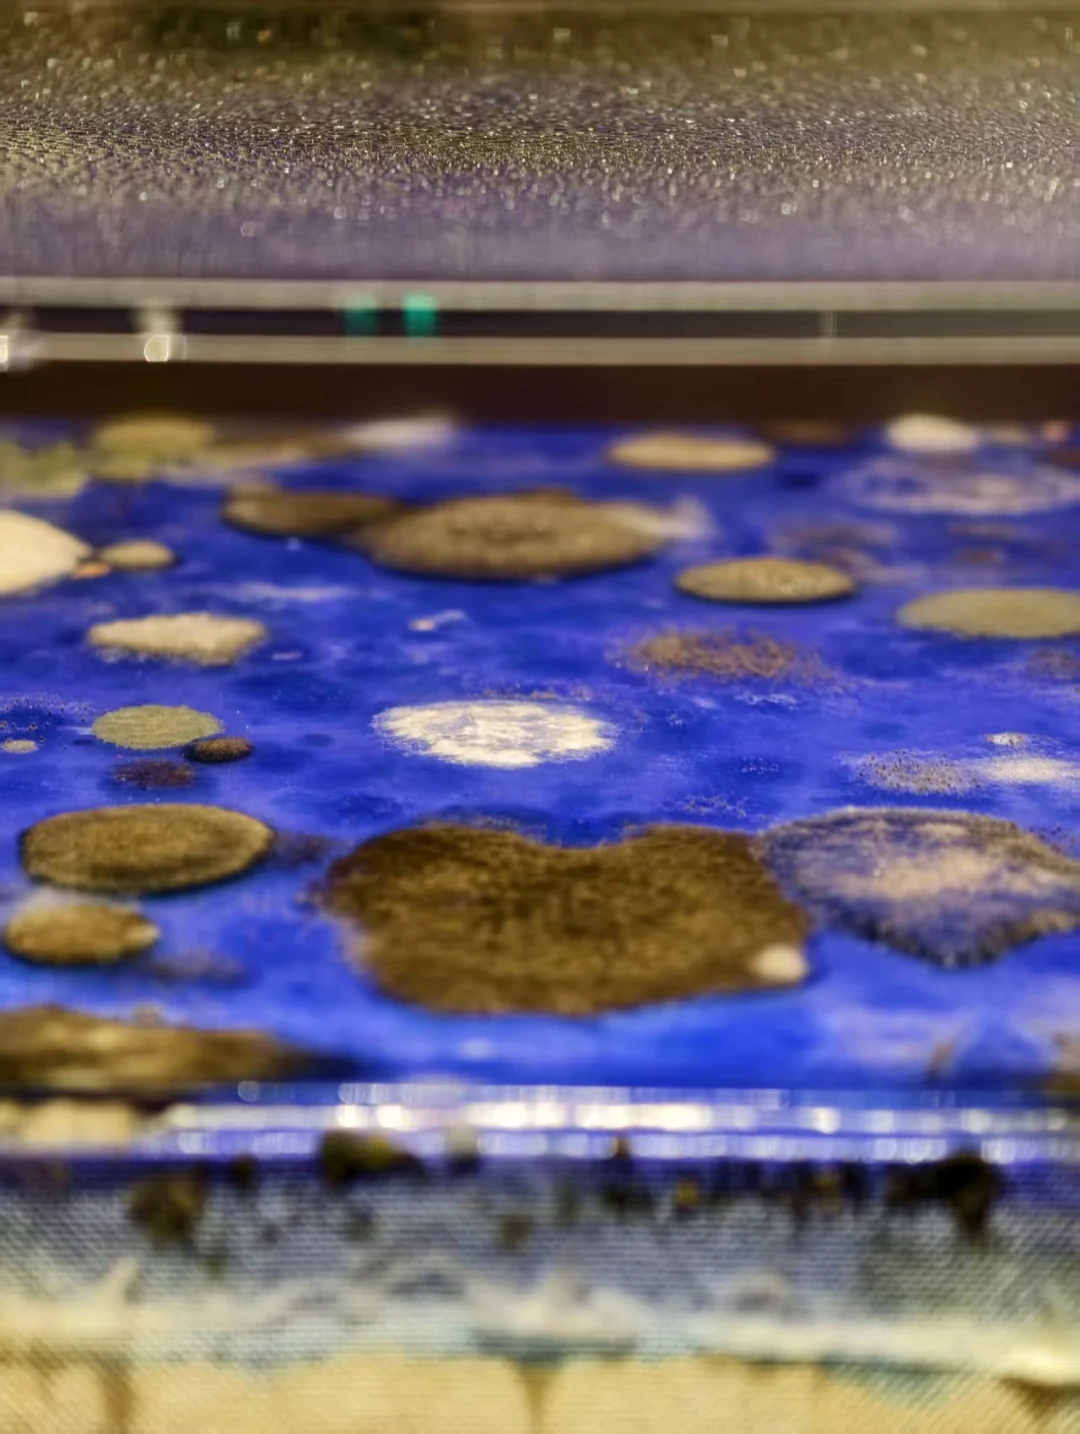

前几天在 798CUBE 看了王郁洋的个展《混成》,出来的时候突然觉得——
如果把跨年放在这里,好像也挺赞的!
光影、机械、生物感混在同一个空间里,你会不自觉放慢脚步。
有几件我会停下来多看一会儿:
🌀《不可名状》——说不清楚,但不想走
🌱《植物20251102》——像未来世界里的生命体
🧠《忘却的记忆》——理性空间里突然被戳到
💙《生物克莱因蓝2025》——安静但很有存在感
如果你也不想把跨年过得太躁,这里给你一个思路👇
跨年夜怎么安排👇
798CUBE 12.31 晚上会开放夜场,灯光暗下来后,空间比白天更安静,零点也有倒计时,灯光亮起的那一刻,会让人记住这一秒。
跨年亮点速览 🌙
夜间看展|艺术福袋盲盒|深夜潜入计划|零点倒计时|夜场优惠票
不吵、不赶进度,但很有记忆点。
适合想安静、认真地走进新一年的人 🌌